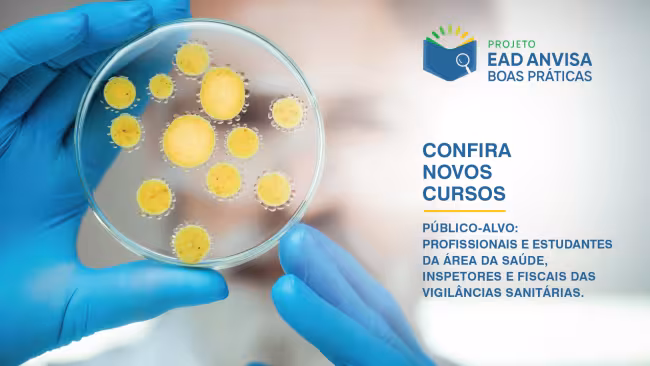
Novos cursos EAD qualificam profissionais da saúde para inspeções sanitárias

Clique aqui para acessar o Relatório Anual dos Hospitais Proadi-SUS.
Notícias
Em meio a uma pandemia como a do novo coronavírus, que já causou milhares de mortes, cientistas de todo o mundo buscam encontrar tratamentos ou vacinas que sejam eficazes na luta…
Os incidentes associados ao cuidado de saúde, em particular os que causam danos ao paciente, representam uma elevada morbidade e mortalidade nos sistemas de saúde. A área de…
O papel da ciência é de inegável importância para o desenvolvimento da sociedade. Na área da saúde, a pesquisa exige um cuidado ainda maior quando h…
Resultados parciais foram apresentados em uma reunião científica com a presença de diversos pesquisadores
…Procedimento é inédito no país, mas ainda está em fase experimental, dependendo de liberação da Anvisa.
…
Para marcar o Dia Mundial de Combate ao Câncer Bucal, no domingo (31), pesquisadores do Hospital Moinhos de Vento fazem um alerta. Em pesquisa inédita, eles descobriram que a preval…
Profissionais e estudantes da área da saúde, inspetores e fiscais das vigilâncias sanitárias estaduais e municipais podem se inscrever…
Assista ao terceiro vídeo da série
O engajamento da alta liderança de um hospital junto aos colaboradores é…
Assista ao segundo vídeo da série
O projeto Saúde em Nossas Mãos preparou mais um conteúdo educativo para…
Assista ao vídeo sobre huddle de segurança, metodologia que garante a qualidade do cuidado e segurança do paciente na UTI
O…
Serviço de 0800 foi demandado pelo Ministério da Saúde e faz parte da força-tarefa de ações em combate ao Coronaví…